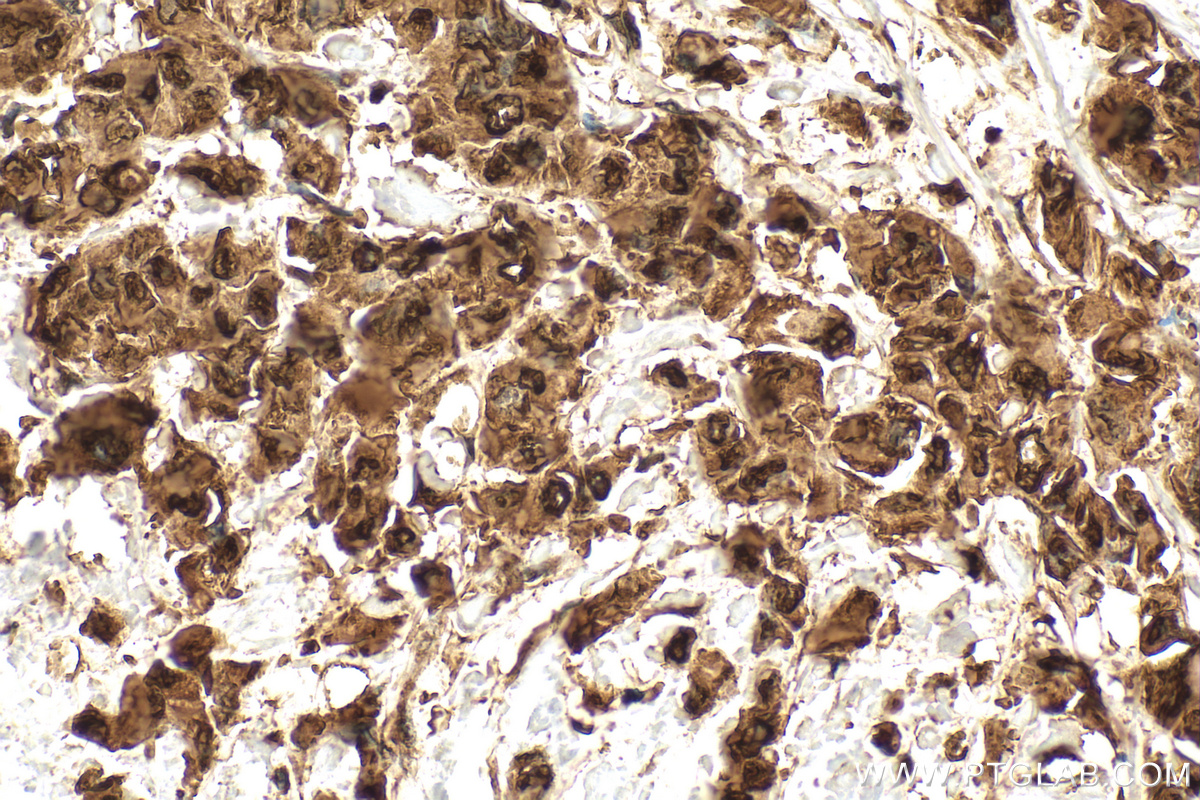
Immunohistochemistry (IHC) staining of human breast cancer tissue using HSP70 Polyclonal antibody (10995-1-AP)

Tested Applications
| Positive WB detected in | A431 cells, human urine exosomes tissue, HEK-293 cells, HeLa cells, Jurkat cells, mouse kidney, rat kidney, A549 cells, mouse brain |
| Positive IP detected in | mouse brain tissue |
| Positive IHC detected in | human breast cancer tissue, human colon tissue, human liver cancer tissue, mouse skin tissue Note: suggested antigen retrieval with TE buffer pH 9.0; (*) Alternatively, antigen retrieval may be performed with citrate buffer pH 6.0 |
| Positive IF/ICC detected in | HeLa cells, HepG2 cells |
| Positive FC (Intra) detected in | HeLa cells |
Recommended dilution
| Application | Dilution |
|---|---|
| Western Blot (WB) | WB : 1:5000-1:50000 |
| Immunoprecipitation (IP) | IP : 0.5-4.0 ug for 1.0-3.0 mg of total protein lysate |
| Immunohistochemistry (IHC) | IHC : 1:500-1:2000 |
| Immunofluorescence (IF)/ICC | IF/ICC : 1:200-1:800 |
| Flow Cytometry (FC) (INTRA) | FC (INTRA) : 0.25 ug per 10^6 cells in a 100 µl suspension |
| It is recommended that this reagent should be titrated in each testing system to obtain optimal results. | |
| Sample-dependent, Check data in validation data gallery. | |
Published Applications
| KD/KO | See 9 publications below |
| WB | See 319 publications below |
| IHC | See 14 publications below |
| IF | See 26 publications below |
| IP | See 1 publications below |
| ELISA | See 1 publications below |
| CoIP | See 5 publications below |
Product Information
10995-1-AP targets HSP70 in WB, IHC, IF/ICC, FC (Intra), IP, CoIP, ELISA applications and shows reactivity with human, mouse, rat samples.
| Tested Reactivity | human, mouse, rat |
| Cited Reactivity | human, mouse, rat, rabbit, chicken, zebrafish, sheep, goat, ostrich, oyster |
| Host / Isotype | Rabbit / IgG |
| Class | Polyclonal |
| Type | Antibody |
| Immunogen |
CatNo: Ag1446 Product name: Recombinant human HSP70 protein Source: e coli.-derived, PGEX-4T Tag: GST Domain: 291-641 aa of BC009322 Sequence: IDFYTSITRARFEELCSDLFRSTLEPVEKALRDAKLDKAQIHDLVLVGGSTRIPKVQKLLQDFFNGRDLNKSINPDEAVAYGAAVQAAILMGDKSENVQDLLLLDVAPLSLGLETAGGVMTALIKRNSTIPTKQTQIFTTYSDNQPGVLIQVYEGERAMTKDNNLLGRFELSGIPPAPRGVPQIEVTFDIDANGILNVTATDKSTGKANKITITNDKGRLSKEEIERMVQEAEKYKAEDEVQRERVSAKNALESYAFNMKSAVEDEGLKGKISEADKKKVLDKCQEVISWLDANTLAEKDEFEHKRKELEQVCNPIISGLYQGAGGPGPGGFGAQGPKGGSGSGPTIEEVD Predict reactive species |
| Full Name | heat shock 70kDa protein 1A |
| Calculated Molecular Weight | 70 kDa |
| Observed Molecular Weight | 66-70 kDa |
| GenBank Accession Number | BC009322 |
| Gene Symbol | HSP70 |
| Gene ID (NCBI) | 3303 |
| RRID | AB_2264230 |
| Conjugate | Unconjugated |
| Form | Liquid |
| Purification Method | Antigen affinity purification |
| UNIPROT ID | P0DMV8 |
| Storage Buffer | PBS with 0.02% sodium azide and 50% glycerol, pH 7.3. |
| Storage Conditions | Store at -20°C. Stable for one year after shipment. Aliquoting is unnecessary for -20oC storage. 20ul sizes contain 0.1% BSA. |
Background Information
-
What is Hsp70/HSP1A?
HSP1A is a member of the Hsp70 (heat shock protein 70) proteins that act as molecular chaperones ensuring correct protein folding and preventing protein aggregation. Hsp70 protein production is greatly induced by various stress stimuli, including high temperature and toxins. Its expression is often elevated in various cancers.
-
FAQs for Hsp70
a. I cannot detect Hsp70 by western blotting
HSP70s are typically expressed at low levels under normal physiological conditions but are dramatically up-regulated in response to cellular stress. Try to always include cell lysate from cells subjected to stress conditions as a positive control.
b. What loading control can I use for cellular stress experiments with Hsp70?
Choosing a loading control antibody is an important step in western blotting experimental setup. We highly recommend using more than one loading control while developing new cellular stress assays to ensure that a given treatment does not alter expression of house-keeping genes. Hsp70 has a molecular size of 70 kDa, so we recommend using GAPDH (36 kDa), actin (42 kDa), or tubulin (50-55 kDa). More information on our control antibodies can be found here: https://www.ptglab.com/news/blog/loading-control-antibodies-for-western-blotting/.
Protocols
| Product Specific Protocols | |
|---|---|
| FC protocol for HSP70 antibody 10995-1-AP | Download protocol |
| IF protocol for HSP70 antibody 10995-1-AP | Download protocol |
| IHC protocol for HSP70 antibody 10995-1-AP | Download protocol |
| IP protocol for HSP70 antibody 10995-1-AP | Download protocol |
| WB protocol for HSP70 antibody 10995-1-AP | Download protocol |
| Standard Protocols | |
|---|---|
| Click here to view our Standard Protocols |
Publications
| Species | Application | Title |
|---|---|---|
Gastroenterology PTEN deficiency facilitates exosome secretion and metastasis in cholangiocarcinoma by impairing TFEB-mediated lysosome biogenesis | ||
Nat Cell Biol Caspase-2 is a condensate-mediated deubiquitinase in protein quality control | ||
Nat Cell Biol Heat stress activates YAP/TAZ to induce the heat shock transcriptome.
| ||
Mol Cancer CircEZH2/miR-133b/IGF2BP2 aggravates colorectal cancer progression via enhancing the stability of m6A-modified CREB1 mRNA. | ||
Adv Sci (Weinh) Reprogramming Lung Redox Homeostasis by NIR Driven Ultra-Small Pd Loaded Covalent Organic Framework Inhibits NF-κB Pathway for Acute Lung Injury Immunotherapy |
Reviews
The reviews below have been submitted by verified Proteintech customers who received an incentive for providing their feedback.
FH PK (Verified Customer) (08-14-2024) |
![]() |
FH Scott (Verified Customer) (05-22-2024) | 20µg of protein was loaded and antibody was incubated overnight at 4oC following a total protein stain. The band appeared at the expected size. Precision plus protein standard ladder #1610373.
![]() |
FH Nin (Verified Customer) (01-28-2023) | A very good antibody to probe HSP70 by WB.
![]() |
FH Tsimafei (Verified Customer) (12-04-2022) | 20µg of the total protein were used. Incubation was done for 2h at room temperature
![]() |
FH Guorong (Verified Customer) (03-22-2022) | Excellent performance with a specific band of expected size
|
FH Luxi (Verified Customer) (11-23-2020) | This antibody works well in my tissue. It binds to the nuclear and cytosol Hsp70s.
|